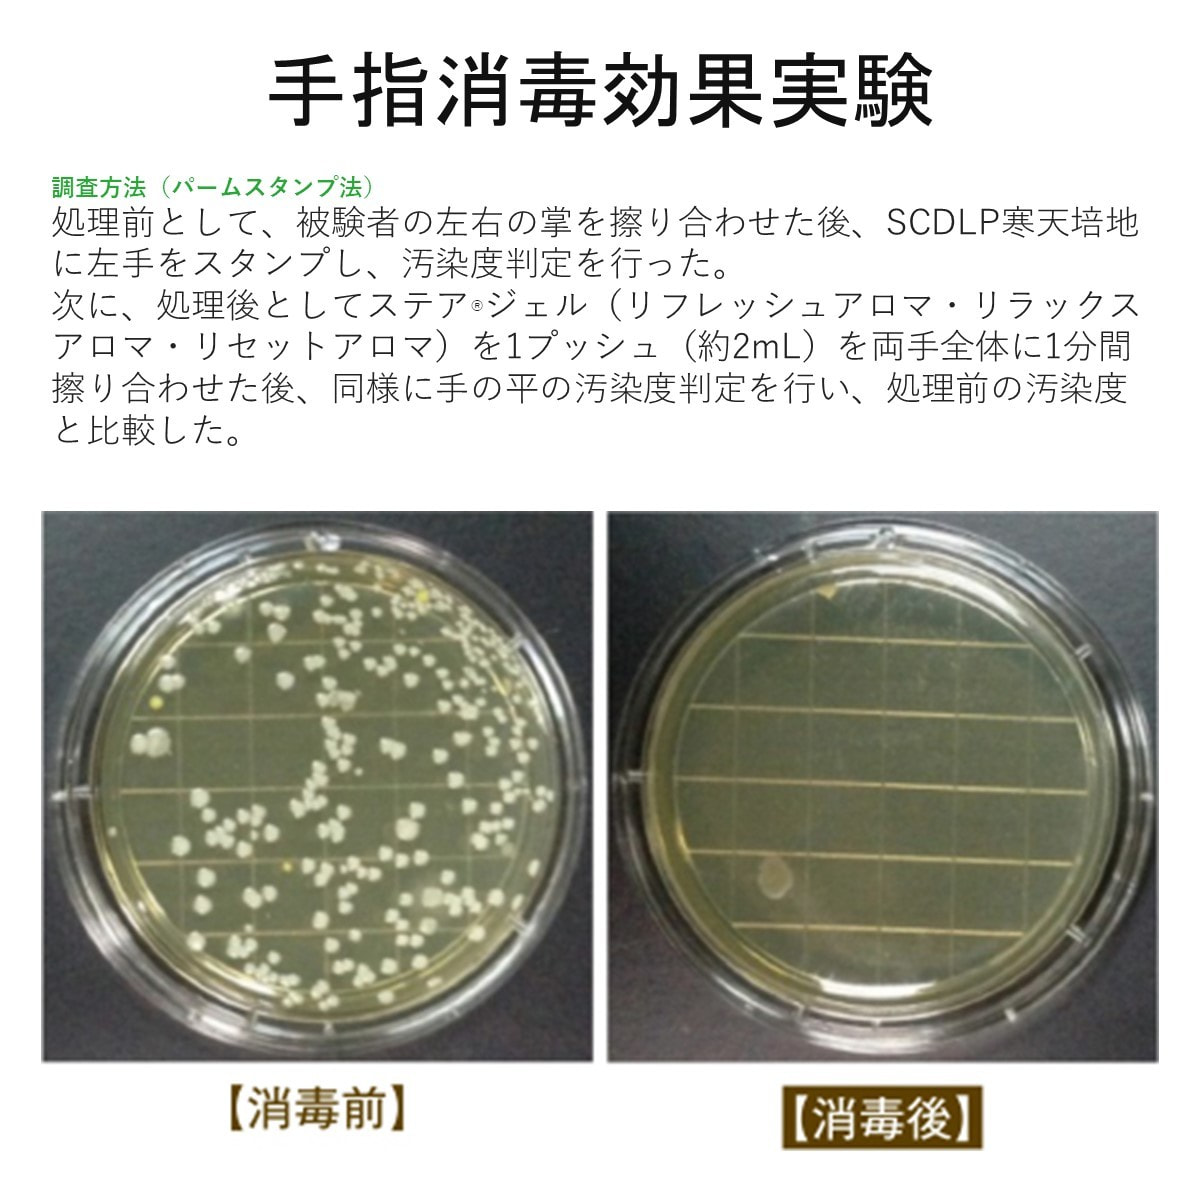

ステアジェル リフレッシュアロマ 300mL
ブランド:
カワモト
通常注文
¥来店会員限定
この商品は物流センター(ビューティガレージ倉庫)出荷商品です
医療の現場で支持されています【指定医薬部外品】
手指衛生遵守率向上の為に・・・
ふんわり天然アロマが香るゲル状の手指消毒剤
▶天然アロマオイルがふんわり香るゲル状手指消毒剤です。
▶爽やかな柑橘系の香り、やさしいラベンダー系の香り、すっきりとしたミント系の香りがあります。
▶「生活の木」のアロマオイルを配合しています。
▶有効成分のエタノールにより、優れた手指消毒効果を有します。
▶保湿成分プロピレングリコールを配合しています。
▶連続して使用しても、べとつきが少ないです。
ステア®ジェル(アロマ)には、「生活の木」のアロマオイルを配合しています。
◆リフレッシュ 爽やかな柑橘系の香り
グレープフルーツ:前向きで明るい気分をもたらす
レモングラス :集中力を取り戻す
ライム :頭をすっきりとさせる
◆リラックス やさしいラベンダー系の香り
ラベンダー :やさしく心癒される
オレンジスイート:心を元気にする
グレープフルーツ:前向きで明るい気分をもたらす
◆リセット すっきりしたミント系の香り
ペパーミント :集中力を高める
ライム :頭をすっきりとさせる
ユーカリ :よどんだ心を浄化する
商品情報
商品番号:0000000000045203
商品コード:148381
商品名:ステアジェル リフレッシュアロマ 300mL
お届け目安:2025-12-12
注意事項
【返品について】
こちらの商品は、お客さま都合での返品をお受けできない返品不可商品です。
有用成分
エタノール、ヒアルロン酸Naほか
仕様
内容量:300mL
指定医薬部外品
生産国:日本
×